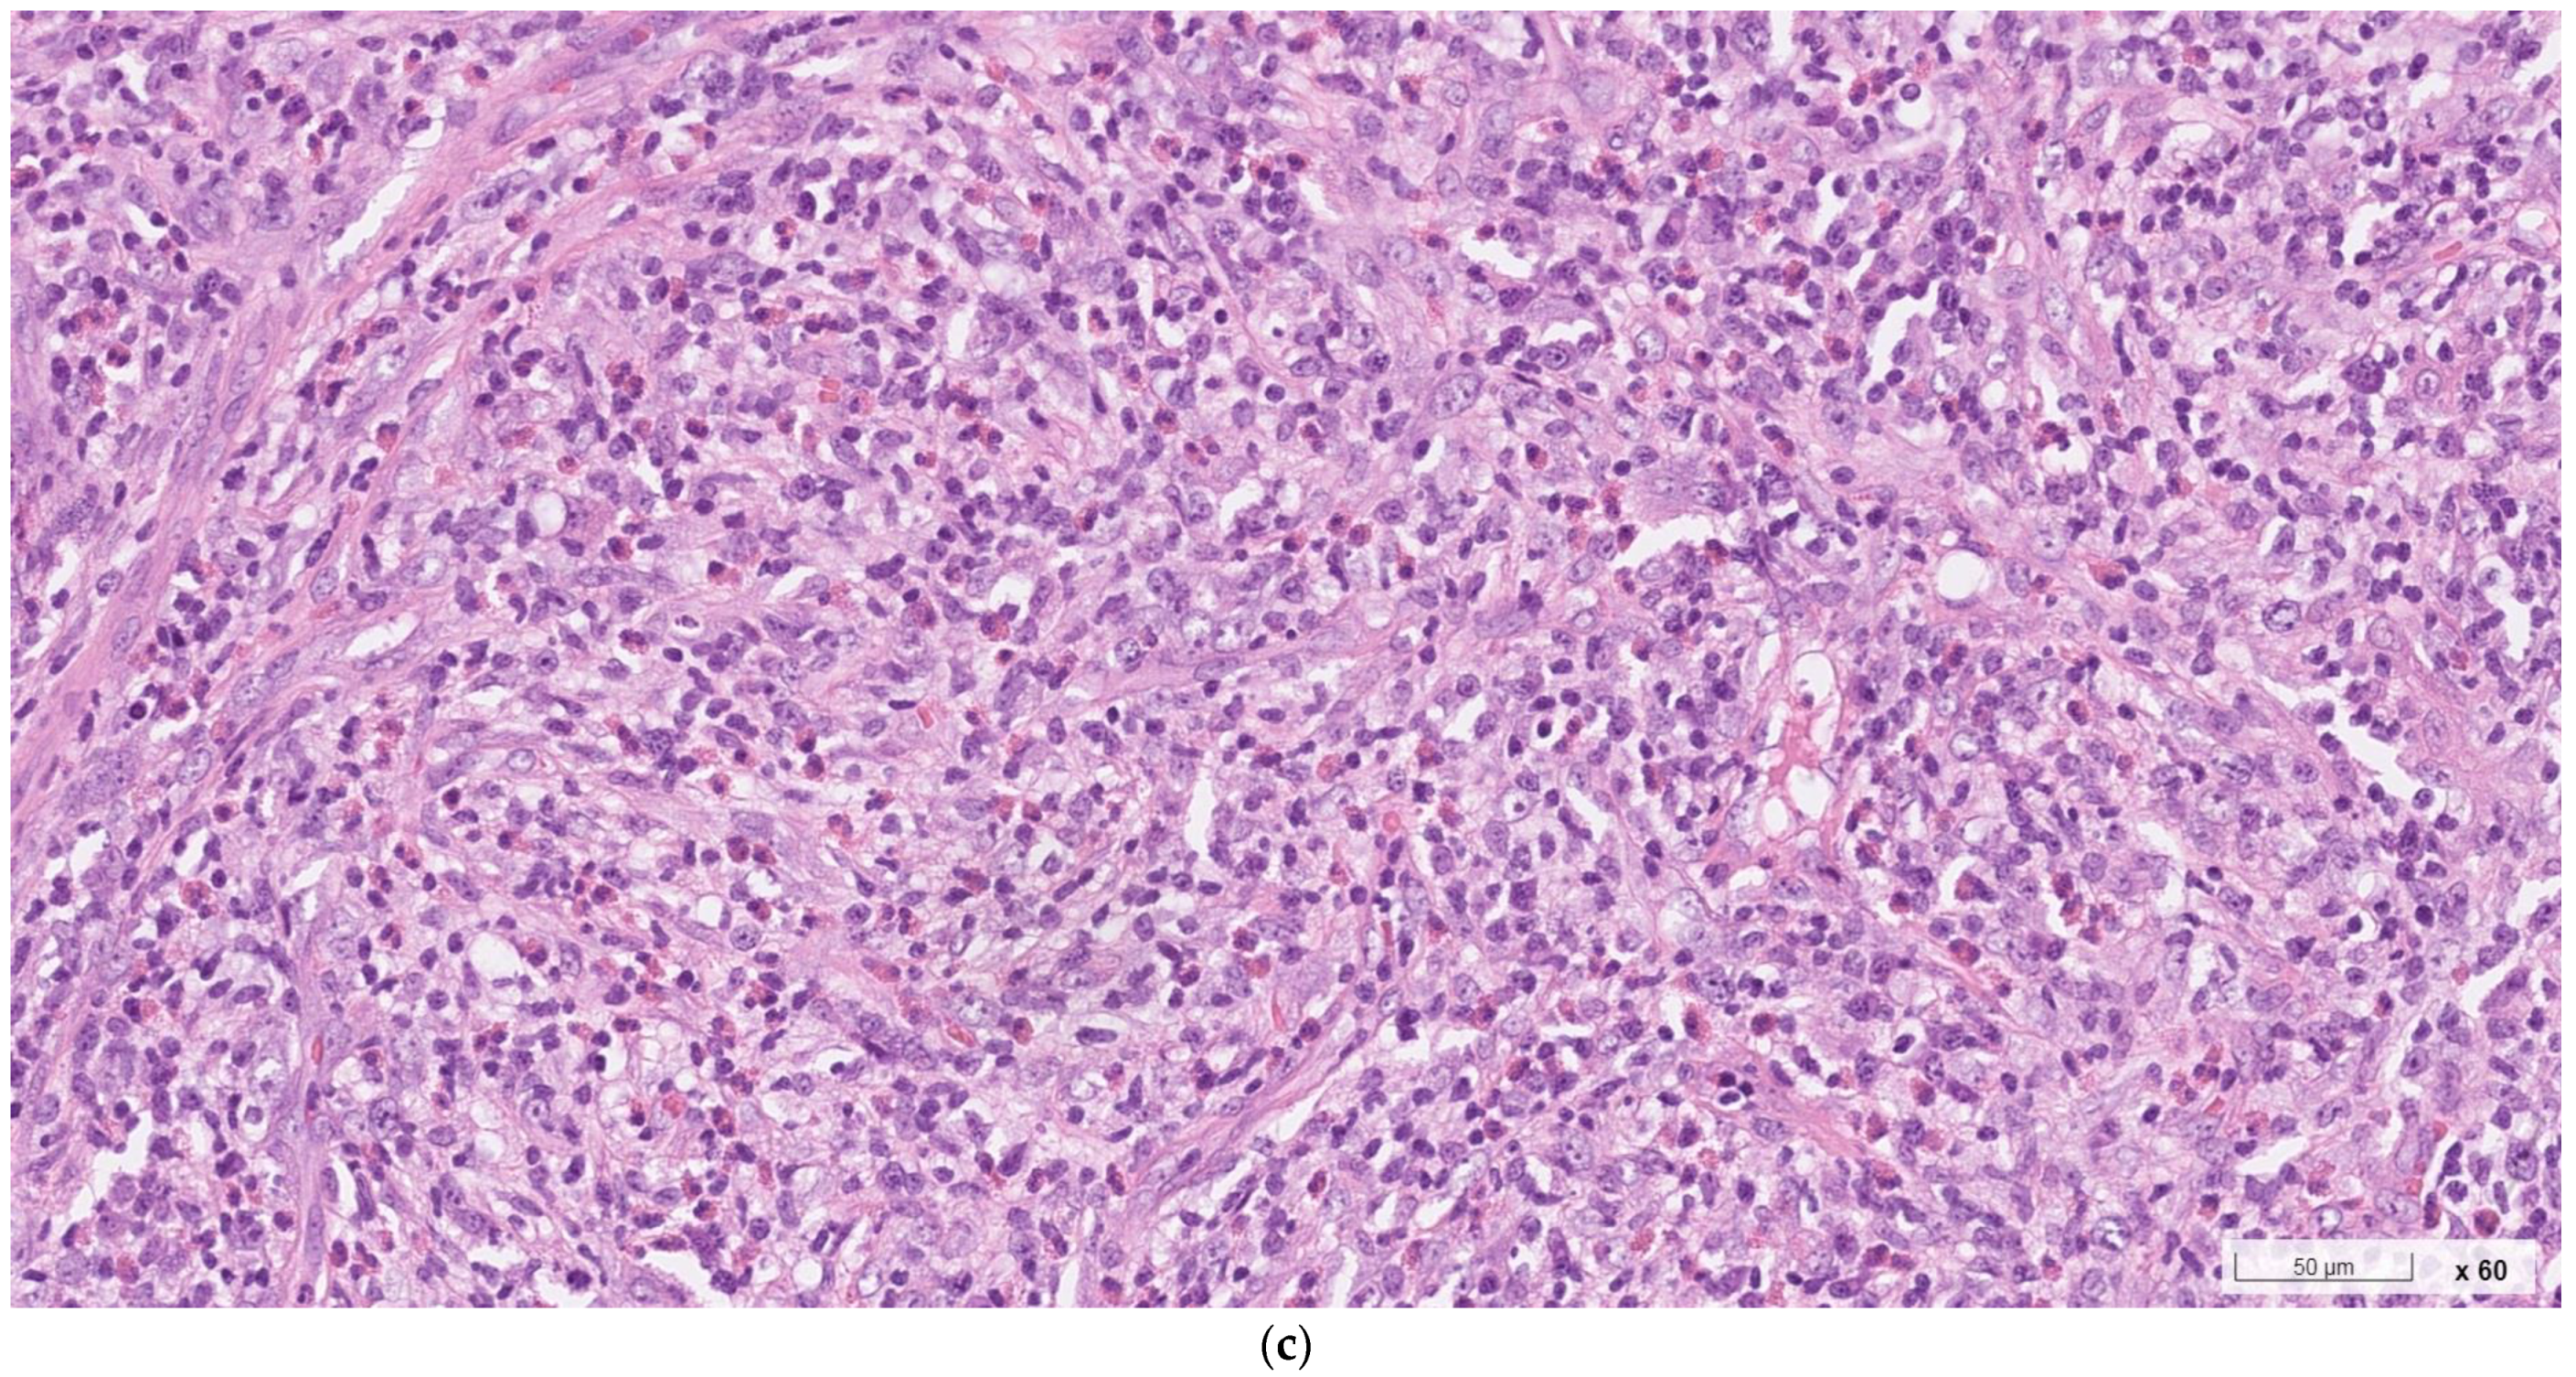
Ijms 24 07666 g002b Ijms 24 07666 g002b

Coexisting Nodular Sclerosis Hodgkin Lymphoma and Kimura’s Disease: A Case Report and Literature Review
Abstract
1. Introduction
2. Case Report
3. Discussion
4. Conclusions
Supplementary Materials
Author Contributions
Funding
Institutional Review Board Statement
Informed Consent Statement
Data Availability Statement
Acknowledgments
Conflicts of Interest
References
- Lee, C.-C.; Yu, K.-H.; Chan, T.-M. Kimura’s disease: A clinicopathological study of 23 cases. Front. Med. 2022, 9, 1069102. [Google Scholar] [CrossRef] [PubMed]
- Kimm, H.T.; Szeto, C. Eosinophilic hyperplastic lymphogranuloma, comparison with Mikulicz’s disease. Chin. Med. J. 1937, 23, 670–699. [Google Scholar]
- Kimura, T.; Yoshimura, S.; Ishikawa, E. On the unusual granulation combined with hyperplastic changes of lymphatic tissues. Trans. Soc. Pathol. Jpn. 1948, 37, 179–180. [Google Scholar]
- Wang, X.; Ng, C.S.; Yin, W. A comparative study of Kimura’s disease and IgG4-related disease: Similarities, differences and overlapping features. Histopathology 2021, 79, 801–809. [Google Scholar] [CrossRef]
- King, R.L.; Tan, B.; Craig, F.E.; George, T.I.; Horny, H.P.; Kelemen, K.; Orazi, A.; Reichard, K.K.; Rimsza, L.M.; Wang, S.A.; et al. Reactive eosinophil proliferations in tissue and the lymphocytic variant of hypereosin-ophilic syndrome, 2019 Society for Hematopathology/European association for haematopathology workshop report. Am. J. Clin. Pathol. 2020, 155, 211–238. [Google Scholar] [CrossRef]
- Gao, Y.; Chen, Y.; Yu, G.Y. Clinicopathologic study of parotid involvement in 21 cases of eosinophilic hyperplastic lym-phogranuloma (Kimura’s disease). Oral Surg. Oral Med. Oral Pathol. Oral Radiol. Endod. 2006, 102, 651–658. [Google Scholar] [CrossRef]
- Hashida, Y.; Higuchi, T.; Nakajima, K.; Ujihara, T.; Murakami, I.; Fujieda, M.; Sano, S.; Daibata, M. Human polyomavirus 6 with the Asian–Japanese Genotype in Cases of Kimura disease and angiolymphoid hyperplasia with eosinophilia. J. Investig. Dermatol. 2020, 140, 1650–1653.e1654. [Google Scholar] [CrossRef]
- Kottler, D.; Barète, S.; Quéreux, G.; Ingen-Housz-Oro, S.; Fraitag, S.; Ortonne, N.; Deschamps, L.; Rybojad, M.; Flageul, B.; Crickx, B.; et al. Retrospective Multicentric Study of 25 Kimura Disease Patients: Emphasis on Therapeutics and Shared Features with Cutaneous IgG4-Related Disease. Dermatology 2015, 231, 367–377. [Google Scholar] [CrossRef]
- Sato, R.; Bandoh, N.; Goto, T.; Ichikawa, H.; Uemura, A.; Suzuki, S.; Yamaguchi, T.; Aimono, E.; Nishihara, H.; Katada, A.; et al. Kimura disease presenting with buccal mass: A case report and literature review. Head Neck Pathol. 2020, 15, 657–662. [Google Scholar] [CrossRef]
- Zhang, G.; Li, X.; Sun, G.; Cao, Y.; Gao, N.; Qi, W. Clinical analysis of Kimura’s disease in 24 cases from China. BMC Surg. 2020, 20, 1. [Google Scholar] [CrossRef]
- Katagiri, K.; Itami, S.; Hatano, Y.; Yamaguchi, T.; Takayasu, S. In vivo expression of IL-4, IL-5, IL-13 and IFN-γ mRNAs in peripheral blood mononuclear cells and effect of cyclosporin A in a patient with Kimura’s disease. Br. J. Dermatol. 1997, 137, 972–977. [Google Scholar] [CrossRef] [PubMed]
- Kimura, Y.; Pawankar, R.; Aoki, M.; Niimi, Y.; Kawana, S. Mast cells and T cells in Kimura’s disease express increased levels of interleukin-4, interleukin-5, eotaxin and RANTES. Clin. Exp. Allergy 2002, 32, 1787–1793. [Google Scholar] [CrossRef] [PubMed]
- Munemura, R.; Maehara, T.; Murakami, Y.; Koga, R.; Aoyagi, R.; Kaneko, N.; Doi, A.; Perugino, C.A.; Della-Torre, E.; Saeki, T.; et al. Distinct disease-specific Tfh cell populations in 2 different fibrotic diseases: IgG4-related disease and Kimura disease. J. Allergy Clin. Immunol. 2022, 150, 440–455.e17. [Google Scholar] [CrossRef] [PubMed]
- Arul, J.; Senthil, N.; Marappa, L. Unusual and rare case of generalised lymphadenopathy: Kimura’s disease. BMJ Case Rep. 2018, 2018, 225020. [Google Scholar] [CrossRef]
- Gopinathan, A.; Tan, T. Kimura’s disease: Imaging patterns on computed tomography. Clin. Radiol. 2009, 64, 994–999. [Google Scholar] [CrossRef]
- Horikoshi, T.; Motoori, K.; Ueda, T.; Shimofusa, R.; Hanazawa, T.; Okamoto, Y.; Ito, H. Head and neck MRI of Kimura disease. Br. J. Radiol. 2011, 84, 800–804. [Google Scholar] [CrossRef]
- O’Malley, D.P.; Grimm, K.E. Reactive lymphadenopathies that mimic lymphoma: Entities of unknown etiology. Semin. Diagn. Pathol. 2013, 30, 137–145. [Google Scholar] [CrossRef]
- Wang, T.-F.; Liu, S.-H.; Kao, C.-H.K.; Chu, S.-C.; Kao, R.-H.; Li, C.-C. Kimura’s Disease with Generalized LymphadenopathyDemonstrated by Positron Emission Tomography Scan. Intern. Med. 2006, 45, 775–778. [Google Scholar] [CrossRef]
- Yu, M.; Wang, Z.; Zhao, J.; Wu, F. Lymphadenopathy Due to Kimura’s Disease Mimicking Lymphoma on FDG PET/CT. Clin. Nucl. Med. 2019, 44, 299–300. [Google Scholar] [CrossRef]
- Beyazit, Y.; Haznedaroglu, I.C.; Aksu, S.; Kekilli, M.; Uner, A.; Agbaht, K.; Sungur, A.; Koca, E.; Goker, H.; Ozcebe, O.I. Changing clinical manifestations of a T-peripheral lymphoma: From hypereosinophilic syndrome to questionable Kimura’s disease resulting in parotid mass. Leuk. Lymphoma 2006, 47, 357–360. [Google Scholar] [CrossRef]
- Kojima, M.; Yokoo, H.; Yoshida, T.; Jinbo, T.; Nakamura, S. Peripheral T-cell lymphoma resembling Kimura’s disease. Letter to the editor. Apmis 2008, 116, 212–214. [Google Scholar] [CrossRef] [PubMed]
- Chim, C.S.; Fung, A.; Shek, T.W.H.; Liang, R.; Ho, W.K.; Kwong, Y.L. Analysis of Clonality in Kimura’s Disease. Am. J. Surg. Pathol. 2002, 26, 1083–1086. [Google Scholar] [CrossRef] [PubMed]
- Jang, K.-A.; Ahn, S.-J.; Choi, J.-H.; Sung, K.-J.; Moon, K.-C.; Koh, J.-K.; Shim, Y.-H. Polymerase chain reaction (PCR) for human herpesvirus 8 and heteroduplex PCR for clonality assessment in angiolymphoid hyperplasia with eosinophilia and Kimura’s disease. J. Cutan. Pathol. 2001, 28, 363–367. [Google Scholar] [CrossRef] [PubMed]
- Ye, P.; Wei, T.; Yu, G.-Y.; Wu, L.-L.; Peng, X. Comparison of Local Recurrence Rate of Three Treatment Modalities for Kimura Disease. J. Craniofacial Surg. 2016, 27, 170–174. [Google Scholar] [CrossRef] [PubMed]
- Lee, C.-C.; Feng, I.-J.; Chen, Y.-T.; Weng, S.-F.; Chan, L.-P.; Lai, C.-S.; Lin, S.-D.; Kuo, Y.-R. Treatment algorithm for Kimura’s disease: A systematic review and meta-analysis of treatment modalities and prognostic predictors. Int. J. Surg. 2022, 100, 106591. [Google Scholar] [CrossRef]
- Chen, Y.; Wang, J.; Xu, F.; Zeng, C.; Liu, Z. Clinicopathological features and prognosis of Kimura’s disease with renal involvement in Chinese patients. Clin. Nephrol. 2016, 85, 332–339. [Google Scholar] [CrossRef]
- Ren, S.; Li, X.Y.; Wang, F.; Zhang, P.; Zhang, Y.; Li, G.S.; Wang, L.; Zhong, X. Nephrotic syndrome associated with Kimura’s disease: A case report and literature review. BMC Nephrol. 2018, 19, 316. [Google Scholar] [CrossRef]
- Brice, P.; de Kerviler, E.; Friedberg, J.W. Classical Hodgkin lymphoma. Lancet 2021, 398, 1518–1527. [Google Scholar] [CrossRef]
- Piris, M.A.; Medeiros, L.J.; Chang, K.-C. Hodgkin lymphoma: A review of pathological features and recent advances in pathogenesis. Pathology 2019, 52, 154–165. [Google Scholar] [CrossRef]
- Chuang, S.-S.; Chen, S.-W.; Chang, S.-T.; Kuo, Y.-T. Lymphoma in Taiwan: Review of 1347 neoplasms from a single institution according to the 2016 Revision of the World Health Organization Classification. J. Formos. Med. Assoc. 2017, 116, 620–625. [Google Scholar] [CrossRef]
- Health Promotion Administration Ministry of Health and Welfare Taiwan (n.d.). Cancer Registry Annual Report 2020. Available online: https://www.hpa.gov.tw/File/Attach/16434/File_20339.pdf (accessed on 19 February 2023).
- Akkaya, I.; Oylumlu, E.; Ozel, I.; Uzel, G.; Durmus, L.; Ciraci, C. NLRC4 Inflammasome-Mediated Regulation of Eosinophilic Functions. Immune Netw. 2021, 21, e42. [Google Scholar] [CrossRef] [PubMed]
- Driscoll, J.; Aslam, I.; Malek, E. Eosinophils upregulate PD-L1 and PD-L2 expression to enhance the immunosuppressive microenvironment in multiple myeloma. Blood 2017, 130, 4417. [Google Scholar]
- An, G.; Acharya, C.; Feng, X.; Wen, K.; Zhong, M.; Zhang, L.; Munshi, N.C.; Qiu, L.; Tai, Y.T.; Anderson, K.C. Osteoclasts promote immune suppressive microenvironment in multiple myeloma: Therapeutic implication. Blood 2016, 128, 1590–1603. [Google Scholar] [CrossRef] [PubMed]

Disclaimer/Publisher’s Note: The statements, opinions and data contained in all publications are solely those of the individual author(s) and contributor(s) and not of MDPI and/or the editor(s). MDPI and/or the editor(s) disclaim responsibility for any injury to people or property resulting from any ideas, methods, instructions or products referred to in the content. |
© 2023 by the authors. Licensee MDPI, Basel, Switzerland. This article is an open access article distributed under the terms and conditions of the Creative Commons Attribution (CC BY) license (https://creativecommons.org/licenses/by/4.0/).
Share and Cite
Lee, C.-C.; Chang, S.-Y.; Teng, W.-C.; Wu, C.-J.; Liu, C.-H.; Huang, S.-W.; Wu, C.-E.; Yu, K.-H.; Chan, T.-M. Coexisting Nodular Sclerosis Hodgkin Lymphoma and Kimura’s Disease: A Case Report and Literature Review. Int. J. Mol. Sci. 2023, 24, 7666. https://doi.org/10.3390/ijms24087666
Lee C-C, Chang S-Y, Teng W-C, Wu C-J, Liu C-H, Huang S-W, Wu C-E, Yu K-H, Chan T-M. Coexisting Nodular Sclerosis Hodgkin Lymphoma and Kimura’s Disease: A Case Report and Literature Review. International Journal of Molecular Sciences. 2023; 24(8):7666. https://doi.org/10.3390/ijms24087666
Chicago/Turabian StyleLee, Chih-Chun, Sing-Ya Chang, Wen-Chieh Teng, Chih-Ju Wu, Chi-Hung Liu, Szu-Wei Huang, Chiao-En Wu, Kuang-Hui Yu, and Tien-Ming Chan. 2023. "Coexisting Nodular Sclerosis Hodgkin Lymphoma and Kimura’s Disease: A Case Report and Literature Review" International Journal of Molecular Sciences 24, no. 8: 7666. https://doi.org/10.3390/ijms24087666
APA StyleLee, C.-C., Chang, S.-Y., Teng, W.-C., Wu, C.-J., Liu, C.-H., Huang, S.-W., Wu, C.-E., Yu, K.-H., & Chan, T.-M. (2023). Coexisting Nodular Sclerosis Hodgkin Lymphoma and Kimura’s Disease: A Case Report and Literature Review. International Journal of Molecular Sciences, 24(8), 7666. https://doi.org/10.3390/ijms24087666

